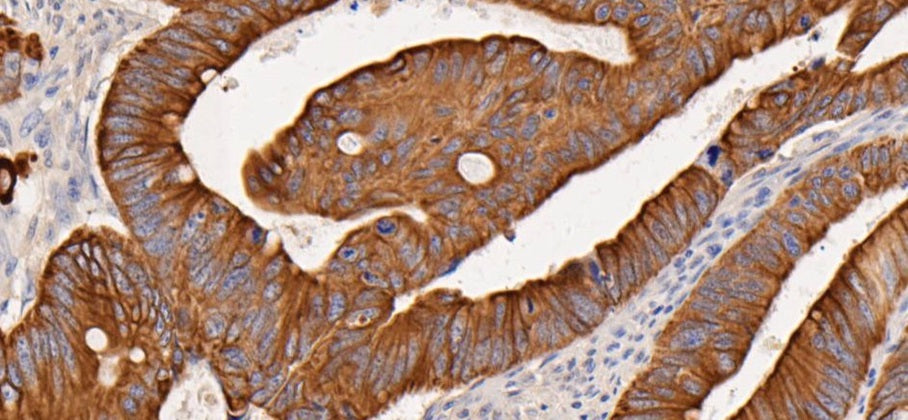

HUABIO offers comprehensive polyclonal antibody services, providing custom antibody production in mouse, rat, rabbit, SPF animals, and other species. We deliver end-to-end solutions, covering everything from antigen design and peptide synthesis to animal immunization, antibody purification, and rigorous quality control with ELISA testing. All our polyclonal antibodies are produced in an AAALAC International-accredited and OLAW-assured facility, ensuring high-quality and reliable results.
Highlights
Rabbit Polyclonal Antibody (pAb) Service Details
| Service | Description | Duration | Deliverables | Method |
|---|---|---|---|---|
| immunogen preparation |
1. Conventional peptide projects (13-18aa, purity >85%) 2. Modified peptide project A (monophosphorylation/monoacetylation) 3. Modified peptide project B (dual phosphorylation/lactylation/crotonylation/succinylation/methylation) 4. Prokaryotic protein project C (<1000bp gene fragment synthesis + protein expression and purification, purity >85%) 5. Prokaryotic protein project D (customer provides expression plasmid, only protein expression and purification is performed, purity >85%) 6. Eukaryotic protein project E (<1500bp gene fragment synthesis + protein expression and purification, purity >85%) 7. Eukaryotic protein project F (1500-2500bp gene fragment synthesis + protein expression and purification, purity >85%) |
3-8 weeks (depends on immunogen types) | Peptide report, Protein report | Mass Spectrometry Report for peptides, SDS-PAGE result for proteins |
| Rabbit Immunization and Serum Titer Test |
2 rabbit, 7mg immunogens at least (>85% purity, >0.5mg/ml), serum titer standard 1:64000 OD450>0.6; |
8-12 weeks | Antiserum report | Indirect ELISA |
| Antibody Purification | Affinity purification of rabbit pAb | 2 weeks | Purified antibody and indirect ELISA data | Indirect ELISA |
| Antibody Delivery | Stored in PBS buffer or clients' request buffer | / | / | / |
When should you choose polyclonal over monoclonal
Polyclonal antibodies recognize multiple epitopes, making them especially effective against complex or poorly characterized antigens; they generate stronger signals for low-abundance targets due to their multi-epitope binding; they’re generally more cost-effective to produce; and their broader binding profile allows detection of more antigen variants. When perfect batch-to-batch consistency isn’t essential, their slight variability still delivers reliable assay performance.